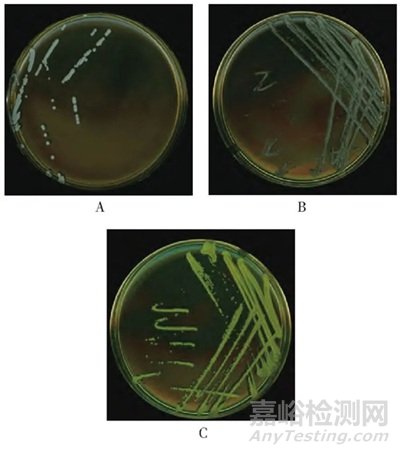
3家制藥企業(yè)臭氧消毒后潔凈車間微生物群落分析

目的:研究制藥企業(yè)潔凈車間經(jīng)臭氧消毒后微生物群落的組成及分布規(guī)律�,分析臭氧消殺效果����,為制藥企業(yè)相同空間消毒方式提供數(shù)據(jù)參考。方法 采用基質(zhì)輔助激光解吸電離飛行時(shí)間質(zhì)譜(MALDI-TOF MS)技術(shù)和全自動(dòng)微生物分析系統(tǒng)(VITEK®2Compact)鑒定方法�,對(duì)收集的浮游菌和沉降菌進(jìn)行鑒定分析。結(jié)果 776株菌均鑒定到屬水平����,消毒前427株菌,消毒后339株菌�,A、B�、C 3家企業(yè)減少比例分別為22%、19%和23%�。消毒前后優(yōu)勢(shì)菌屬均為葡萄球菌屬、芽孢桿菌屬����、微球菌屬,消毒效果最明顯為微球菌屬和考克菌屬�,消毒效果最差為芽孢桿菌屬。其中人員更衣區(qū)污染菌量減少比例最少����,企業(yè)B在消毒后的A級(jí)灌裝區(qū)仍能采集到污染菌,說(shuō)明臭氧消毒未完全覆蓋可能出現(xiàn)的微生物污染風(fēng)險(xiǎn)�。
結(jié)論:臭氧消毒是潔凈車間空間消毒的常用方式�,定期分析消毒后微生物種群����,進(jìn)一步提高消毒水平,保證藥品生產(chǎn)有效性�、安全性。
??Part.00引 言
微生物污染是影響藥品質(zhì)量的重要因素����,也是引發(fā)藥品安全事故的重要原因[1]���。目前�,多數(shù)制藥企業(yè)結(jié)合藥品生產(chǎn)特性�,多采用不同級(jí)別潔凈車間來(lái)最大限度降低微生物、微粒和熱原的污染���,從而減少終產(chǎn)品的微生物污染���。各國(guó)的藥品生產(chǎn)質(zhì)量管理規(guī)范和相關(guān)指導(dǎo)原則都對(duì)潔凈車間提出較高要求[2-4],制藥企業(yè)不僅需要建立完善的微生物環(huán)境監(jiān)測(cè)計(jì)劃����,了解生產(chǎn)過(guò)程的微生物負(fù)載情況,更要掌握其污染微生物的分布、組成���、來(lái)源�,確立警戒限與糾偏限���,以便對(duì)潔凈區(qū)人員操作規(guī)程���、清潔和消毒程序、設(shè)施設(shè)備的管理等生產(chǎn)全過(guò)程進(jìn)行風(fēng)險(xiǎn)評(píng)估�,保證潔凈區(qū)處于正常的運(yùn)行和良好的受控狀態(tài)。
目前�,制藥企業(yè)對(duì)潔凈車間污染微生物的研究大多停留在先根據(jù)培養(yǎng)特征進(jìn)行分類,再通過(guò)幾個(gè)基礎(chǔ)生化反應(yīng)試驗(yàn)檢索微生物的所屬范圍���,最后選擇合適的生化試驗(yàn)條件將微生物鑒別到種[5]�,該方法操作繁瑣����、周期長(zhǎng),當(dāng)藥品受到微生物污染時(shí)�,往往會(huì)出現(xiàn)溯源難、應(yīng)變慢等問(wèn)題����。采用基質(zhì)輔助激光解吸電離飛行時(shí)間質(zhì)譜(matrix-assisted laser desorption ionization timeof-flight mass spectrometry,MALDI-TOF MS)或16S核糖體RNA(16S rRNA)基因測(cè)序方法���,對(duì)表面蛋白或DNA進(jìn)行檢測(cè),快速鑒定到微生物種或?qū)?���,且?duì)不常見(jiàn)的生化型及難培養(yǎng)的微生物等也有很好的鑒定能力,是近幾年對(duì)大容量污染菌鑒定的主要技術(shù)手段���,在復(fù)雜的菌種鑒定方面有廣闊的應(yīng)用前景[6-8]。
本研究對(duì)以臭氧為空間消毒的A���、B���、C 3家制藥企業(yè),按照《中國(guó)藥典(2020年版)》四部要求進(jìn)行采樣���,采用MALDI-TOF MS和全自動(dòng)微生物分析系統(tǒng)(VITEK®2 Compact)對(duì)搜集的環(huán)境菌株進(jìn)行鑒定����。依據(jù)鑒定結(jié)果�,統(tǒng)計(jì)3家制藥企業(yè)環(huán)境菌的組成�、數(shù)量����、分布規(guī)律,分析臭氧消殺效果���,為相同空間消毒方式制藥企業(yè)提供數(shù)據(jù)參考�。
Part.01材料與方法
1.1主要儀器
MALDI-TOF MS和VITEK®2 Compact全自動(dòng)微生物分析系統(tǒng)購(gòu)自法國(guó)生物梅里埃公司����;DM500生物顯微鏡(德國(guó)Leica公司);二級(jí)生物安全柜(新加坡ESCO);CHP-9080型隔水式恒溫培養(yǎng)箱(上海一恒科學(xué)儀器有限公司)�;STIK BI-450A型生化培養(yǎng)箱(施都凱儀器設(shè)備有限公司)。
1.2培養(yǎng)基與試劑
胰酪大豆胨瓊脂(tryptic soytone agar,TSA)培養(yǎng)基(批號(hào):221127)�、沙氏葡萄糖瓊脂(sabouraud dextrose agar,SDA)培養(yǎng)基(批號(hào):220506)、革蘭氏染色液(批號(hào):221026)���、霉菌染色液(批號(hào):221206)均購(gòu)自北京陸橋技術(shù)股份有限公司���;VITEK®MS-α-氰基-4-羥基肉桂酸(α-Cyano-4-hydroxycinnamic acid,CHCA,批號(hào):1009312950)����、革蘭氏陰性細(xì)菌鑒定卡(VITEK2 GN���,批號(hào):2412606503)、革蘭氏陽(yáng)性細(xì)菌鑒定卡(VITEK2 GP�,批號(hào):2422260503)、棒狀桿菌鑒定卡(VITEK2CBC���,批號(hào):2462188203)���、厭氧菌及棒狀桿菌鑒定卡(VITEK2 ANC,批號(hào):2442208503)及芽孢桿菌鑒定卡(VITEK2 BCL�,批號(hào):2392931203)均購(gòu)自法國(guó)生物梅里埃公司。
1.3方法
1.3.1 采集與培養(yǎng)
企業(yè)A�、B、C設(shè)定臭氧濃度均為20~30 mg/m3�,其中A企業(yè)為大容量注射劑���,平均環(huán)境溫度為22℃���,平均濕度為45%,潔凈區(qū)分為A����、C�、D級(jí)�,臭氧消毒時(shí)間為2 h,采集時(shí)間為2023年1月���;B企業(yè)為小容量注射劑�,平均環(huán)境溫度為20℃���,平均濕度為48%���,潔凈區(qū)分為A、B���、C級(jí)����,臭氧消毒時(shí)間為1 h�,采集時(shí)間為2023年7月;C企業(yè)為原料藥����,平均環(huán)境溫度為23℃,平均濕度為45%����,潔凈區(qū)均為D級(jí)���,臭氧消毒時(shí)間為1.5 h,采集時(shí)間為2023年8月����。
依據(jù)《醫(yī)藥工業(yè)潔凈室(區(qū))沉降菌的測(cè)試方法》(GB/T16294-2010)和《醫(yī)藥工業(yè)潔凈室(區(qū))浮游菌的測(cè)試方法》(GB/T 16293—2010)布置采樣點(diǎn),通過(guò)空氣沉降和針孔式采樣器進(jìn)行樣本采集�,采集完成后將TSA平板倒置32.5℃培養(yǎng)箱中培養(yǎng)2~3 d。
1.3.2 分離與純化
挑取TSA平板中菌落�,分別進(jìn)行2次以上TSA或SDA平板劃線分離純化。
1.3.3 微生物的鑒定
取分離純化后的菌株�,進(jìn)行革蘭氏染色或霉菌染色鏡檢,初步判斷所得菌株類型后按照不同儀器要求進(jìn)行菌種鑒定�。
(1) VITEK®2 Compact法:依據(jù)革蘭氏染色鏡檢結(jié)果選取相應(yīng)鑒定卡,制備適宜濃度的菌懸液后進(jìn)行鑒定���。
(2) MALDI-TOF MS法:按照VITEK®MS標(biāo)本準(zhǔn)備流程,加樣于靶點(diǎn)上�,加入1µL CHCA基質(zhì)液,室溫自然揮干���,干燥后放入MALDI-TOF MS儀器中���,啟動(dòng)程序獲取質(zhì)譜圖�,將待測(cè)菌株與儀器數(shù)據(jù)庫(kù)進(jìn)行匹配����,利用Myla軟件進(jìn)行查詢。
Part.02結(jié)果
2.1環(huán)境菌的種類
(1)推動(dòng)藥材GAP的實(shí)施
對(duì)3家企業(yè)臭氧消毒前后進(jìn)行浮游菌和沉降菌收集���,共計(jì)766株菌�,其中A企業(yè)消毒前收集108株菌�,消毒后收集84株菌;B企業(yè)消毒前收集208株菌����,消毒后收集169株菌;C企業(yè)消毒前收集111株菌����,消毒后收集86株菌。對(duì)766株菌進(jìn)行鏡檢染色�,消毒前427株菌為24株真菌、265株G+球菌�、37株G-球菌、59株G+桿菌、42株G-桿菌�;消毒后收集339株菌為11株真菌、215株G+球菌���、33株G-球菌�、57株G+桿菌����、23株G-桿菌。具體見(jiàn)圖1����。
圖1 3家制藥企業(yè)收集菌株形態(tài)特征統(tǒng)計(jì)圖
2.2環(huán)境菌的分離純化
(1)提取工藝優(yōu)化
對(duì)收集的環(huán)境菌分別進(jìn)行傳代,并同時(shí)進(jìn)行鏡檢����,使用紛騰H9掃描儀,采用RGB模式����,分辨率600 ppi,對(duì)2~4代進(jìn)行1∶1掃描�。圖2結(jié)果顯示,部分分離的菌落形態(tài)特征有明顯變化����,如某株環(huán)境菌2代菌落顏色為白色,革蘭氏染色為陽(yáng)性球菌���;3代菌落為淡黃色���,革蘭氏染色為陽(yáng)性球菌;4代菌落顏色為金黃色�,革蘭氏染色為陽(yáng)性球菌。對(duì)2���、3�、4代菌落分別經(jīng)MALDI-TOF MS鑒定均為藤黃微球菌����,菌落典型特征應(yīng)呈金黃色。因此���,對(duì)收集的環(huán)境菌進(jìn)行傳代不僅可以達(dá)到分離純化的目的����,也有利于環(huán)境菌典型特征恢復(fù)�。
注:A.2代����;B.3代�;C.4代。
圖2 菌株掃描圖
2.3菌株鑒定結(jié)果
對(duì)搜集到776株菌���,經(jīng)MALDI-TOF MS和VITEK®2 Compact鑒定到屬水平占比100%���,對(duì)臭氧消毒前后進(jìn)行數(shù)據(jù)統(tǒng)計(jì)分析,具體見(jiàn)圖3�。消毒前后占比數(shù)量最多的優(yōu)勢(shì)菌屬為葡萄球菌屬、芽孢桿菌屬���、微球菌屬���,臭氧消毒后占比提高的為芽孢桿菌屬,其余菌屬均有所下降���,占比下降最多的為微球菌屬和考克菌屬���。
圖3 3家制藥企業(yè)潔凈車間臭氧消毒前后微生物群落組成圖
注:A.消毒前;B.消毒后�。
統(tǒng)計(jì)臭氧消毒后3種優(yōu)勢(shì)菌屬的菌種類別可得���,企業(yè)A葡萄球菌屬鑒定到屬水平為42株,最多的是表皮葡萄球菌和人葡萄球菌���,均為14株;芽孢桿菌屬鑒定到屬水平為14株����,最多的是枯草芽孢桿菌,為3株���;微球菌屬鑒定到屬水平為4株����,均為藤黃微球菌�。企業(yè)B葡萄球菌屬鑒定到屬水平為42株,最多的是人葡萄球菌和表皮葡萄球菌���,分別為13株和11株���;芽孢桿菌屬鑒定到屬水平為24株,最多的是高度/短小芽孢桿菌和蠟樣芽孢桿菌�,分別為11株和4株�;微球菌屬鑒定到屬水平為35株���,最多的是藤黃微球菌����,為30株���。企業(yè)C葡萄球菌屬鑒定到屬水平為40株����,最多的是腐生葡萄球菌�,為30株;芽孢桿菌屬鑒定到屬水平為7株�,最多的是蠟樣芽孢桿菌,為3株�;微球菌屬鑒定到屬水平為4株,均為藤黃微球菌�,具體見(jiàn)圖4。
圖4 臭氧消毒后葡萄球菌屬�、芽孢桿菌屬、微球菌屬的菌株分布
2.4臭氧消毒前后菌株的分布情況
按照不同潔凈級(jí)別統(tǒng)計(jì)3家制藥企業(yè)臭氧消毒前后菌株的分布情況���,企業(yè)A中在人員更衣區(qū)�、緩沖區(qū)、核心生產(chǎn)區(qū)(C級(jí))消毒后環(huán)境污染菌減少比例最少����,其中人員更衣區(qū)(D級(jí))消毒后檢出環(huán)境污染菌多于消毒前;企業(yè)B中人員更衣區(qū)(B�、C級(jí))、緩沖區(qū)���、衛(wèi)生清潔區(qū)(C級(jí))消毒后環(huán)境污染菌減少比例最少;企業(yè)C中人員更衣區(qū)���、緩沖區(qū)�、核心生產(chǎn)區(qū)(D級(jí))消毒后環(huán)境污染菌減少比例最少����。3家制藥企業(yè)臭氧消毒前后菌株分布情況詳見(jiàn)表1~表3。
表1 企業(yè)A臭氧消毒前后菌株的分布情況
表2 企業(yè)B臭氧消毒前后分布情況
表3 企業(yè)C臭氧消毒前后分布情況
Part.03討論
3.1采集樣本的代表性
本研究選取的3家制藥企業(yè)均符合藥品生產(chǎn)質(zhì)量管理規(guī)范生產(chǎn)車間要求����,潔凈分區(qū)明確,處于同一地域�,潔凈車間溫濕度基本一致,在不同采集時(shí)間�,對(duì)臭氧消毒前進(jìn)行全面采集�,是為了盡可能多地采集環(huán)境污染菌種類和數(shù)量����,收集菌株具有一定的代表性;臭氧消毒濃度基本一致�,對(duì)臭氧消毒后進(jìn)行全面采集,是為了研究在不同條件(包括消毒時(shí)間����、生產(chǎn)工藝、藥品種類)下臭氧的消殺效力����,評(píng)價(jià)臭氧消毒效率,使得出的結(jié)論更具有客觀性���。微生物鑒定方法選擇MALDI-TOF MS和VITEK®2 Compact�,利用鑒定不同原理�,不同數(shù)據(jù)庫(kù),相互驗(yàn)證鑒定結(jié)果���,準(zhǔn)確率高���,鑒定結(jié)果可靠�。
3.2環(huán)境菌分離和純化
本研究收集的臭氧消毒后菌株因受到長(zhǎng)期低營(yíng)養(yǎng)���、化學(xué)消毒劑的作用等因素的影響���,代謝活動(dòng)被抑制,部分菌株不呈典型菌落形態(tài)特征�,生化反應(yīng)不典型,分離劃線需要延長(zhǎng)培養(yǎng)時(shí)間或更換培養(yǎng)條件�,如使用血平板或兼性厭氧條件,對(duì)環(huán)境菌的選擇和鑒定有較大影響���。需要檢驗(yàn)人員具備科學(xué)的判斷,優(yōu)化培養(yǎng)條件���,盡量恢復(fù)環(huán)境菌典型特征����,避免有漏檢���、錯(cuò)檢的環(huán)境微生物存在�。
此外���,進(jìn)行2次以上TSA平板劃線后���,對(duì)培養(yǎng)皿菌落顏色����、形狀�、邊緣、光澤等形態(tài)特征進(jìn)行判定����,對(duì)培養(yǎng)特征一致的培養(yǎng)皿,挑取不同菌落進(jìn)行MALDI-TOF-MS和VITEK®2 Compact鑒定���,有的為相同屬���、不同種,如溶血葡萄球菌和沃氏葡萄球菌����,有的為相同科、不同屬�,如溶酪巨球菌和人葡萄球菌。因此,僅憑培養(yǎng)特征判定是否已經(jīng)達(dá)到分離純化目的是不可靠的���,還需要有適當(dāng)?shù)蔫b定�,判定是否需要繼續(xù)傳代純化�,保證鑒定結(jié)果準(zhǔn)確性。
3.3潔凈區(qū)污染源分析
消毒前共收集427株污染環(huán)境菌����,數(shù)量最多的為葡萄球菌屬,這類菌株常附殖于人的眼����、鼻、口���、耳����、喉���、頭和手[9-10],從事藥品生產(chǎn)的人員由于消毒不徹底�、動(dòng)作幅度過(guò)大、缺乏無(wú)菌操作意識(shí)等原因,帶入人源性污染����。高抗性芽孢桿菌屬和曲霉菌屬?gòu)V泛分布于空氣、土壤和水中�,是自然界常見(jiàn)微生物之一[11],主要存在于物料與包材中���,屬于因滅菌不徹底引入的污染���。微球菌屬污染最多的是藤黃微球菌,占80%以上�,該菌同葡萄球菌屬主要來(lái)源潔凈區(qū)工作人員。不動(dòng)桿菌屬是檢出最多革蘭氏陰性菌���,該類微生物在皮膚和物料上均有檢出����,因粘附力極強(qiáng)�,可能成為貯菌源[12],造成同一區(qū)域多次檢出�,應(yīng)加強(qiáng)對(duì)該菌屬的污染控制,防止擴(kuò)散�。
3.4臭氧消殺效果分析
臭氧是一種強(qiáng)氧化性氣體����,具有高效����、廣譜、無(wú)二次污染�、殺菌徹底等優(yōu)點(diǎn),是常用的空間消毒劑[13]����。3家制藥企業(yè)臭氧消毒時(shí)間均不少于30 min,都是在消毒換氣后立即進(jìn)行全面采樣�。根據(jù)研究可得,臭氧消毒后共收集339株菌����,A、B���、C 3家制藥企業(yè)潔凈車間內(nèi)污染菌減少比例分別為22%����、19%和23%���。消毒前后優(yōu)勢(shì)菌屬均為葡萄球菌屬����、芽孢桿菌屬���、微球菌屬����,消毒效果最明顯為微球菌屬和考克菌屬�,消毒效果最差為芽孢桿菌屬。其中人員更衣區(qū)污染菌量減少比例最少���,企業(yè)B在消毒后的A級(jí)灌裝區(qū)仍能采集到污染菌�,說(shuō)明臭氧消毒未完全覆蓋可能出現(xiàn)的微生物污染風(fēng)險(xiǎn)����,企業(yè)應(yīng)積極分析影響因素,優(yōu)化消毒條件���、聯(lián)合使用紫外線照射或過(guò)氧化氫發(fā)生器等手段����,提高臭氧消毒效力,或?qū)⒊粞跸竞蟪霈F(xiàn)頻次高�、難殺滅的菌種納入表面消毒劑驗(yàn)證范圍,進(jìn)一步提高消殺效果����,保證藥品生產(chǎn)有效性、安全性�。
3.5臭氧消殺效果影響因素分析
根據(jù)調(diào)研,潔凈車間在臭氧消毒時(shí)有以下情況:
(1)因設(shè)施設(shè)備影響部分區(qū)域面積大且距離臭氧發(fā)生端遠(yuǎn)�,無(wú)法全部維持高濃度消毒劑量;
(2)消毒前污染微生物數(shù)量多����、種類多,各種微生物因生物結(jié)構(gòu)不同����,臭氧對(duì)其消殺效果也不同;
(3)污染微生物負(fù)載量大的區(qū)域����,具有團(tuán)聚的趨勢(shì),消毒時(shí)會(huì)有類似臭氧抗性的效果[14];
(4)通常潔凈車間的相對(duì)濕度控制在45%~65%����,小于標(biāo)準(zhǔn)規(guī)定的大于等于70%要求[15],會(huì)影響臭氧消毒器的消毒效果����;
(5)缺乏對(duì)消毒時(shí)間的驗(yàn)證。
綜上所述�,制藥企業(yè)潔凈車間的環(huán)境控制是一項(xiàng)長(zhǎng)期艱巨的任務(wù),建立微生物數(shù)據(jù)庫(kù)���,科學(xué)分析每一項(xiàng)管理措施����,驗(yàn)證合理有效的清潔消毒方式����,最大程度減少微生物污染的可能性,使產(chǎn)品的質(zhì)量處于持續(xù)穩(wěn)定的發(fā)展方向���。
參考文獻(xiàn)
1 劉亞茹 , 余萌 , 肖璜 , 等 . 五家制藥企業(yè)潔凈區(qū)微生物群落分 析 [J]. 中國(guó)藥事 , 2019, 33(7): 796-802. [Liu YR, Yu M, Xiao H, et al. Analysis of microfora in clean areas of five pharmaceutical enterprises[J]. Chinese Pharmaceutical Affairs, 2019, 33(7): 796- 802.] DOI: 10.16153/j.1002-7777.2019.07.012.
2 U.S. Food and Drug Administration. Guidance for industry: sterile drug productsproducedbyasepticprocessing-currentgoodmanufacturingpractice[EB/OL]. (2004-09-01) [2024-12-05]. http://www.fda.gov/media/71026/download.
3 European Commission. EU guideline to good manufacturing practice medicinal products for human and veterinary use. Annex 1: manufacture of sterile medicinal products (The second targeted consultation) [EB/OL]. (2020-02-20) [2024-12-05]. https:// ec.europa.eu/ health/sites/health/ files/files/ gmp/2020_annex1ps_ sterile_medicinal_products_en.pdf.
4 Pharmaceuticals and Medical Devices Agency. Guidance on the manufacture of sterile pharmaceutical products by aseptic processing[EB/OL]. (2011-04-01) [2024-12-05]. http://www. pmda. go.jp/ files/000153543.pdf.
5 中國(guó)藥典 2020 年版 . 四部 [S]. 2020: 503-506.
6 郭 琦 . 基 于 VITEK MS 及 VITEK2 Compact 的 更 年 寧 微 生 物 污 染 調(diào) 查 [J]. 中 成 藥 , 2024, 46(10): 3523-3528. [Guo Q. Investigation of microbial pollution in geng nian ning based on VITEK MS and VITEK2 compact[J]. Chinese Traditional Patent Medicine, 2024, 46(10): 3523-3528.] DOI: 10.3969/ j.issn.1001-1528.2024.10.057.
7 宋明輝 , 李瓊瓊 , 秦峰 , 等 . 無(wú)菌藥品生產(chǎn)企業(yè)過(guò)程污染 微生物菌株庫(kù)的建立及數(shù)據(jù)分析 [J]. 藥物分析雜志 , 2019, 39(11): 1954-1960. [Song MH, Li QQ, Qin F, et al. Establishment and data analysis of a contaminated microorganisms library for sterile pharmaceutical production processes[J]. Chinese Journal of Pharmaceutical Analysis, 2019, 39(11): 1954-1960.] DOI: 10.16155/j.0254-1793.2019.11.05.
8 鄭小玲 , 王征南 , 王知堅(jiān) , 等 . 藥品微生物檢測(cè)實(shí)驗(yàn)室環(huán) 境菌庫(kù)的建立 [J]. 中國(guó)現(xiàn)代應(yīng)用藥學(xué) , 2015, 32(7): 847- 850. [Zheng XL, Wang ZN, Wang ZJ, et al. Establishment of the environmentally microbial library in the drug sterility testing laboratory[J]. Chinese Journal of Modern Applied Pharmacy, 2015, 32(7): 847-850.] DOI:10.13748/j.cnki.issn1007-7693.2015.07.019.
9 甘永琦 , 阮斌 , 零文超 , 等 . 藥品企業(yè)生產(chǎn)車間潔凈環(huán)境沉降菌的鑒定分析 [J]. 藥物分析雜志 , 2020, 40(9): 1684-1691. [Gan YQ, Ruan B, Ling WC, et al. Identification and analysis of sedimentary bacteria of clean environment of production workshop in pharmaceutical manufacturers[J]. Chinese Journal of Pharmaceutical Analysis, 2020, 40(9): 1684-1691.] DOI: 10.16155/j.0254-1793. 2020. 09.21.
10 李南 , 孫麗媛 , 關(guān)奕澤 , 等 . 藥物生產(chǎn)車間污染微生物的快速鑒定和污染微生物資源及信息庫(kù)的建立 [J]. 藥物分析雜志 , 2021, 41(3): 474-483. [Li N, Sun LY, Guan YZ, et al. Rapid identification of contaminated microorganisms in drug production work area and establishment of contaminated microorganism resource bank and database[J]. Chinese Journal of Pharmaceutical Analysis, 2021, 41(3): 474-483.] DOI: 10.16155/j.0254-1793.2021.03.13.
11 Sandle T. A review of clean room microflora: types, trends, and patterns[J]. PDA J Pharm Sci Technol, 2011, 65(4): 392-403. DOI: 10.5731/pdajpst 2011.00765.
12 張弛 , 張建玲 , 薛梅 , 等 . 制藥企業(yè) CNC 區(qū)域微生物數(shù)據(jù)庫(kù)的建立及微生物種群分析 [J]. 中國(guó)生物制品學(xué)雜志 , 2023, 36(12): 1503-1514. [Zhang C, Zhang JL, Xue M, et al. Establishment of CNC regional microbial database and microbia population analysis for pharmaceutical enterprises[J]. Chinese Journal of Biologicals, 2023, 36(12): 1503-1514.] DOl: 10.13200/j.cnki.cjb.000082.
13 曹越 , 帖金鳳 , 晁思琪 , 等 . 一種新型板式臭氧消毒機(jī)對(duì)空氣及物體表面消毒效果研究 [J]. 中國(guó)消毒學(xué)雜志 , 2024, 41(3): 179-182. [Cao Y, Tie JF, Zhao SQ, et al. Study on disinfection effect of a novel plate ozone disinfector on air and object surface[J]. Chinese Journal of Disinfection, 2024, 41(3): 179-182.]DOI: 10.11726/j.issn.1001-7658.2024.03.006.
14 張彭義 , 李惠南 , 楊潔 , 等 . 臭氧用于空氣和表面消毒的研究進(jìn)展 [J]. 安全與環(huán)境學(xué)報(bào) , 2021, 21(3): 1277-1291. [Zhang PY, Li HN, Yang J, et al. Research progress on ozone for air and surface disinfection[J]. Journal of Safety and Environment, 2021, 21(3): 1277-1291.] DOI:10.13637/j.issn.1009-6094.2020.0848.
15 國(guó)家市場(chǎng)監(jiān)督管理總局 , 國(guó)家標(biāo)準(zhǔn)化管理委員會(huì) . 臭氧消毒器衛(wèi)生要求 . GB28232-2020[S]. 2020.
撰稿人 | 曲璐����,程紅杰�,陳超杰,李朋烏���,趙新霞責(zé)任編輯 | 邵麗竹審核人 | 何發(fā)